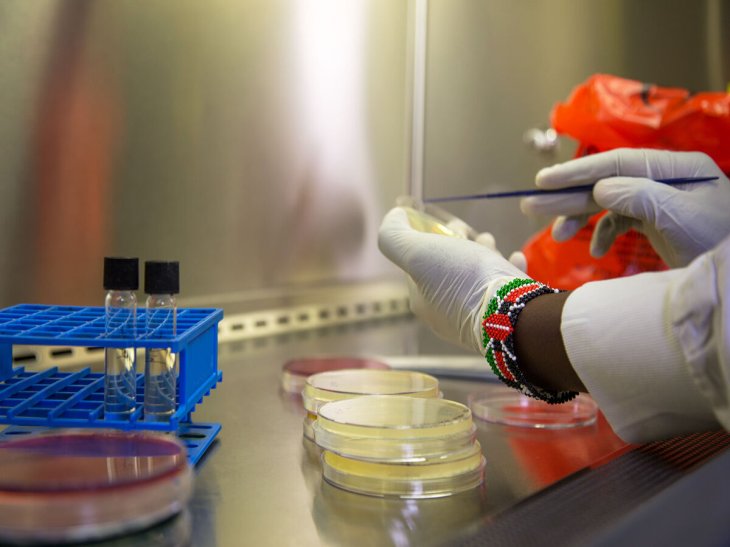
Rs29808 Img 0102 H2

When Will The CO.VID-19 Pandemic End?
Aadhya Khatri - Mar 30, 2020
After weeks of strict measures, including distancing and lockdown, Hubei province, China, has seen the pandemic slowing down, with few or even no new cases
- This Man's Super-Antibody Can Be Diluted 10,000 Times But Still Works Against COVID-19
- These Indian Cities Are Under Lockdown Again In 2021
- India To Review Covishield Vaccine After Report Of Blood Clots Following Vaccination
With so little understanding of CO.VID-19, scientists are having a hard time predicting when we can get our normal life back.
To curb the spread the pandemic, strict orders on social distancing or even curfew are issued. A prime example is the history biggest nation-wide lockdown currently happening in India.
In a matter of days, the lockdown has caused severe consequences on people’s wellbeing, financial situations, and the livelihood of vulnerable groups.
Immunity is key
A critical threshold for the world is when enough people become immune to CO.VID-19, meaning the virus cannot find a suitable new host before leaving the last one. However, the future requires one-third to two-thirds of the population to have this immunity.
There are two paths we can take to ensure that enough people are immune. One is for humans’ bodies to recover and generate immune molecules that can fight off the virus should it tries to infect them again. The other is to find a vaccine, telling the body how to react when it detects the virus without falling ill.
Flattening The Curve
While many organizations are working to develop a vaccine, we may have to wait for months, or even years for a product suitable for commercial use. In the meantime, what governments are betting on is containing the pandemic so that it does not put a strain on the healthcare system that is already overwhelmed.

That is the whole idea of lockdown and travel restriction. If we can prevent the virus from hopping rapidly from one person to the other, we will not see a sudden spike in the number of cases.
One of the most effective ways you can do to avoid spreading the virus is social distancing, meaning maintaining a distance of at least two meters from each other.
An end in sight?
As China achieved some initial success in lowering new cases of CO.VID-19 infection, we now have an example of what we can expect.
After weeks of strict measures, including distancing and lockdown, Hubei province, China, has seen the pandemic slowing down, with few or even no new cases.
That gives us now hope that someday, our country can have the same success. However, it is obvious that ending this disease is difficult. A long lockdown will surely hit the economy hard. It can also have a severe effect on people’s physical and mental health.
However, lifting the order too soon and we will face an even worse consequence.
>>> India May Face A Shortage Of Condoms As CO.VID-19 Cripples Manufacturing
Featured Stories
Features - Mar 24, 2026
How to Use GeForce NOW to Play Video Games Without Actual Hardware
Features - Jan 29, 2026
Permanently Deleting Your Instagram Account: A Complete Step-by-Step Tutorial
Features - Jul 01, 2025
What Are The Fastest Passenger Vehicles Ever Created?
Features - Jun 25, 2025
Japan Hydrogen Breakthrough: Scientists Crack the Clean Energy Code with...
ICT News - Jun 25, 2025
AI Intimidation Tactics: CEOs Turn Flawed Technology Into Employee Fear Machine
Review - Jun 25, 2025
Windows 11 Problems: Is Microsoft's "Best" OS Actually Getting Worse?
Features - Jun 22, 2025
Telegram Founder Pavel Durov Plans to Split $14 Billion Fortune Among 106 Children
ICT News - Jun 22, 2025
Neuralink Telepathy Chip Enables Quadriplegic Rob Greiner to Control Games with...
Features - Jun 21, 2025
This Over $100 Bottle Has Nothing But Fresh Air Inside
Features - Jun 18, 2025
Comments
Sort by Newest | Popular